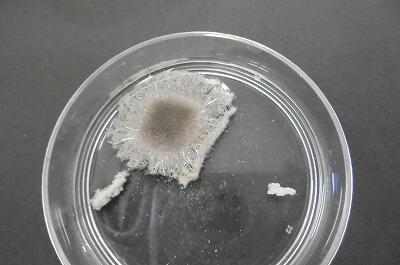

お知らせ/学びの丘日記
新聞掲載のお知らせ(7/30)
7月30日(土)付、宮日こども新聞「学園歌壇」コーナーに、小学部5年生、四位 真麻さんの短歌が掲載されました。
おめでとうございます!
【掲載作品】
あじさいはつゆの季節に顔見せてきれいだなあと思わせる花
夏休みの上学特集③
夏休みの上学特集、PART3です!
毎年、小学部3~6年生が体育大会で披露している、「湯之宮棒踊り」の打合会&講習会を行いました。
お忙しい中、「湯之宮棒踊り保存会」の皆様に来校いただき、「棒踊りの歴史」「衣装や道具」「基本的な踊り」について、職員に指導していただきました。
【「かけ声」「棒の握り方・持ちかえ方」「足運び」等様々なことが分かりました!】
【教えていただき、みるみる上達する職員!】
ふるさとの伝統芸能を正確に継承していく上で、大変貴重な時間となりました。今年の体育大会の「棒踊り」、ぜひ楽しみにしていてください!
保存会の皆様、誠にありがとうございました。
次回は2学期、児童に向けて指導をしていただく予定です。よろしくお願いいたします。
続いて・・・
【第1回学校関係者評価委員会】
今年度の「学校経営方針」「コミュニティスクールに向けて」「学校評価までの流れ」等を説明させていただきました。委員の皆様から貴重なご意見もいただき、今後の学校経営の参考にさせていただきたいと思います。
お忙しい中、来校いただいた皆様、誠にありがとうございました。今後ともどうぞよろしくお願いいたします。
~夏休みの上学特集「つづく」~
夏休みの上学特集②
夏休みの上学特集、PART2

まずは、真夏の暑さに負けず、青春の汗を流す部活動生からです。
【剣道部:木刀を持って「形」の練習中。「えい!」】
【「とう!」】
【ソフトテニス部:私が行くと気持ちのよいあいさつをしてくれました。】
【合唱部】
【素敵なハモリが聞こえてきました。音楽発表会を楽しみにしています!】
続いて・・・
【今日から個人面談が行われています。(29日まで)】
最後に、23日(土)、24日(日)に行われた「西都夏まつり」の夜間巡回補導に参加していただいた皆様・・・
【休日の遅い時間にもかかわらず、ありがとうございました。】
~夏休みの上学特集「つづく」~
新聞掲載のお知らせ(7/23)
7月23日(土)付、宮日こども新聞「学園俳壇」コーナーに、小学部4年生、石川 翔琉さんの作品が掲載されました。
おめでとうございます!
「カブトムシに見とれてとけるアイスクリーム」
夏休みの上学①(7/22)
【夏休み、誰もいない教室・・・】
やはり、子ども達の声が聞こえないのは寂しいですね・・・。
先生達はというと・・・
きたる2学期に向けて、充電期間です。
様々な研修に取り組み、教師力アップを目指します。
まずは・・
【先日まで実施されていた、相互参観授業の事後研究会】
【それぞれの授業のよかった点、課題を語り合い、授業改善につなげていきます。】
続いて・・・
【緊急時の対応についてのシミュレーション研修】
【役割演技を行いながら、対応を確認していきます。】
【シミュレーションを行うことで、課題についてもしっかり共有することができました。】
もしもに備えて、非常に大切な実践的な研修となりました。
最後にもう1本・・
【授業におけるICTの効果的な活用を目指して、宮崎大学とオンラインで結んでの研修会です。】
【一人一台タブレットが導入され、授業で積極的に活用している「ロイロノート」について・・・】
【すご~~い!こんなこともできるんだ!】
2学期すぐに活用できそうな機能もたくさん教えていただき、大変勉強になった研修会でした。
~夏休みの上学「つづく」~
作文がラジオから流れます!
小学部6年生、藤田 蓮さんの作文「6年生になって頑張ること」がMRTラジオ「私たちの作文」で放送されます。
〇 7月28日(木) 16:50~
(再放送 8月4日(木)午前5時~)
おめでとうございます!
終業の日特集②(7/20)
終業の日特集、PART2
【1学期終業式です】
【児童代表作文発表「1学期を振り返って」】
〇 字をていねい書くことを心がけた。
〇 困っている人に優しくすることができた。
〇 2学期は、苦手なことにも精一杯挑戦したい。
【生徒代表作文発表】
〇 全員と仲良くなりたいと思い、積極的に話しかけた。
〇 様々なことに挑戦することができた。(学級委員長や英語の暗唱)
〇 クラスのみんなと協力・団結しながら最高の2学期にしていきたい。
【39日間の長い夏休み、1日1日を大切に!】
最後に表彰関係・・・
【図画・ポスターの部】
*撮影時のみマスクを外しています。
【剣道スポーツ少年団】
【野球スポーツ少年団 *23日(土)に日南市で行われる県大会に出場します。】
これで、終業の日特集はおしまいです。
1学期間、コロナ禍で何かと制約の多い日々でしたが、保護者や地域の方々のご理解、ご協力により、充実した教育活動を行うことができました。誠にありがとうございました。2学期もどうぞよろしくお願いいたします。
それではみなさん・・・
【素敵な夏の思い出を~~!】
*夏休み中も、たま~~にホームページアップします!いつアップするか分からないので、ぜひ、毎日チェックしてみてください!
今日の給食&上学ニュース!(7/20)
終業の日あるある・・
【給食着回収なので・・・】
【今日はエプロンDay!】
【カラフルな給食配膳の時間となりました!】
それでは、1学期最後の給食メニューは、こちら↓
〇コッペパン、牛乳
〇夏野菜のミートソース
〇フルーツジュレ
給食に携わってくださっている全ての方々・・・
【1学期間、栄養のある、おいしい給食をありがとうございました!】
上学ニュース!
本日運命の・・・
【レベコン(レベルアップコンテスト)結果発表です!(給食時間)】
各教科の満点者が、全て読み上げられました。結果は・・・
〇 5教科の満点者の延べ人数
1年生(63名)、2年生(50名)、3年生(53名)と素晴らしい成績でした。また・・・
〇 なんと!5教科全て100点のパーフェクト賞!を獲得した生徒が・・・。
1年生(3名)、2年生(3名)、3年生(2名)
生徒と教師のレベコンに対する真剣な取組によって、生徒の学力がさらにアップしました。
終業の日特集①(7/20)

1学期も最終日。本日終業の日です!
1学期最後の1日を上学っ子達はどう過ごしたのか特集でお届けしていきます。
まずは、小学部5年生。お世話になった教室や特別教室を・・・
【大掃除です!】
【窓ガラスは、ピッカピカ!ガラスがないみたい・・・】
【隅から隅まで、心を込めて・・・】
【グッジョブ!「立つ鳥跡を濁さず」、気持ちよく夏休みに入れますね。】
続いては、終業の日あるある!
【担任の先生から入念に?説明を受けているのは、大事な大事な・・・】
【夏休みの宿題です!!】
【39日分た~~っぷり!】
「明日ありと思う心の仇桜・・・」
計画的に進めていきましょう!
終業の日特集 ~まだまだつづく~
自分の命は自分で守る!(7/19)
夏休みを前に・・・
「自分の命は自分で守る!」ための実践的学習。
もしもの時の着衣泳の様子をお届けします。
【中学部3年生の様子】
着衣のまま、プールに入ると、あちらこちらで・・・
「おも~~い!」「体が動きにくい」etc。若干パニック状態。
問答無用でそのまま・・・
【浮いたり、潜ったり・・・】
【クロール】
【平泳ぎに背泳ぎ(いつもの実力が発揮できない中学生です!)】
【小学部5、6年生も体験中。万一のとき一番長く、楽に泳ぐ方法・・】
【背浮きやチョウチョ泳ぎを特訓中】
【「たすけて~~~!」誰かが溺れていても、決して助けに飛び込んではいけません!そんなときは・・・】
【大人を呼びに行くこと。そして、身の回りにある浮く物を投げてあげる。(ペットボトル、浮き輪、ランドセル・・・)】
全国で水の事故が多発しています。今回の着衣泳を通して、服のまま水に入る(落ちる)ことの危険性、そして、もしもの時の自分の命を守る方法についてしっかり学ぶことができた子ども達です。
今日の給食&上学ニュース!(7/20)
【今日のメニュー】
〇麦ご飯、牛乳
〇厚揚げの中華煮
〇ナムル
食べ物クイズです!
「10回息を吹くと出てくる食べ物は何でしょう?」
正解は・・・
【豆腐です!*フーフーフー・・・とお(10)フー】
「畑のお肉」といわれるほど良質なタンパク質を含む大豆から作られる豆腐です。成長期の子ども達にとって、とても大切な食材ですね!
上学ニュース!
いよいよ明日、1学期終業の日です。
そして、39日間の長い夏休みに入ります。
【中学部3年生の教室前に掲示してあるものは・・・】
【勝負の夏~ギャップを埋める旅2022~】
【漢字に込めた思い「苦手なこと、大変なことを乗り越える」
【「毎日机に向かう。向上心を忘れない」】
中学部3年生にとっては、「勝負の夏」ですね。暑さに負けず、充実した日々を過ごしてください。
小さな旅⑨(7/15)
「小さな旅」PART9です!
まずは、朝の中学部3年生の教室で起こっていたドラマ?からです。
担任不在の朝の会。一人の少年が前に出て、担任の代わりに講話を行っていました。さすが中学3年生ともなると違いますねぇ!
続いては、同じく朝の光景。
【少年が持っているものは・・・、まさか・・・】
【やっぱり・・・。へびの抜け殻さ、さ、財布に入れておくとお金が貯まるんだよね。】
時は流れ、昼休み・・・
【熱い陽射しの中、熱いアスファルトの上で集まっている集団発見。何をしているの?】
【理科で作ったのかな?光電池を利用した動くおもちゃ・・。元気よく動いていましたが、日光を遮ると・・・】
【ピタッ!止まった・・・】
【小学6年生はクラスみんなでドッジボール】
【担任の先生も楽しそう・・・】
中学生は、今日も制服のままサッカー!15分経過・・・
【だれた~~~。あち~~~。】
以前、中学部の理科の授業で「紫キャベツを使った焼きそば作り」をお伝えしましたが、実験後の焼きそばは・・・
【いろいろな人へプレゼント!↑大喜びの小学生!早く食べたくてじ~~と焼きそばを見つめます!】
【よかったねぇ~~!中学部の優しいお兄ちゃん、だ~い好き!!】
小さな旅⑨~おしまい~
切磋琢磨②
相互参観授業のPART2です。
中学部数学「文字の式」の学習です。
【めあて「画用紙をとめるために必要なマグネットの個数を求める方法を考えよう」】
【一人一人、タブレットに文字を使った式と考え方を書き込んでいきます。】
様々な生徒の考え方が出てきて、見ていてワクワクするような授業でした。
続いて・・・
中学部音楽。めあて「どのようなことを考えて音楽表現を工夫すればいいのだろう。」
【パートリーダーを中心に、合唱曲「故郷」を練習中】
【自分の歌声を録音し、最初に録音した歌声と比較します。】
音楽の授業でも一人一台タブレットは大いに活躍してくれています。
~切磋琢磨「おしまい!」~
今日の給食&上学ニュース!(7/15)
今日のメニューは・・・
〇 ひじきご飯
〇 いわしのトマト煮
〇 八杯汁(はちはいじる)
と、給食にはめずらしい料理がずらり。特に・・・
八杯汁???恥ずかしながら初めて聞く料理です。
宮崎の郷土料理で、特に延岡でよく食べられているそうです。名前の由来は、8杯おかわりするほどおいしい、豆腐一丁で8人分作れる、等諸説あります。
【とろみがあって、とてもおいしかったです!】
上学ニュース!
1年生は最近、「あさがお祭り」・・・
【あさがおの絵に・・・】
【あさがおのたたき出し・・・】
【こんなにきれいな色が出せるんだ・・ビックリ!】
それでは・・・
【本物のあさがおと一緒に・・・。1年生の笑顔の花もたくさん咲いていました!】
切磋琢磨①
教師同士が、お互いの授業を参観し合い、授業力向上を目指していく「相互参観授業」の様子を特集でお届けしていきます。
今年度は、全教師、年2回研究授業を行う予定です。
まずは、小学部2年生体育「マット運動」から・・・
【友達の演技をタブレットで撮影し・・】
【映像を確認し、アドバイスし合います。その結果・・】
【こんなにかっこいい側転に・・・】
【ハンドスプリング・・。レベルの高さにビックリです!】
続いては・・・
【中学部社会の授業です。授業の初めから、積極的に手が挙がります。】
【イタリアについて調べたことを自作のプレゼンで発表】
【「日本とイタリアの暮らしではどのような違いがあるのだろうか?」小グループで積極的に意見交換をしていました。】
社会大好き!意欲的に調べ学習に取り組む生徒たちの姿が印象的でした。
~つづく~
職業講話(7/14)
本日行われた、中学部総合的な学習の時間「職業講話」の様子をお届けします。
生徒が「働く」ことの意義や目的について、しっかり学び、考えるための機会として、毎年実施しているキャリア教育講話会です。
5つの会場に分かれて「実際に現場で働く方々」の生の声を聞いていきました。
【美容師コーナー】
【はさみの持ち方について・・・】
【説明を聞いて、上手に動かすことができるようになりました!(右の子は違うはさみを出していますが・・・)】
【自衛官コーナー】
【生徒達から次々と質問が・・・。「背面飛行で大変なことは何ですか?」「やっぱりトム・クルーズはすごいんですか?(役を全部自分でやっていたから)」etc】
【警察官コーナー:生徒が体験しているのは・・・】
【黒い粉を使って・・・】
【指紋検出体験。く~~っきり手形(指紋)が浮かび上がってきて、生徒達もビックリ!】
【保育士コーナー】
【保育士になるために学生時代に学んだこと】
【看護師コーナー】
【防護服試着体験】
【では、手術を始めます!】
【「はーい、リラックスしてくださいねぇ」血圧・脈拍測定中・・】
【聴診器で心音を聞いています。「先生、私生きています!」】
【生徒代表お礼の言葉】
講師の方々に、働くことの大切さや喜び、社会で生きていくために必要な力などを話していただき、生徒達にとって、とても貴重な時間となりました。
来校していただいた皆様、誠にありがとうございました。
今日の給食&上学ニュース!(7/14)
【今日のメニュー】
〇新富産野菜カレー
〇グリーンサラダ
今日は、地産地消の日です。新富町産の食材は・・・

【カレーに入っているなすと豚肉。サラダに入っているきゅうり】
題して、「おいし~んとみ夏カレー&サラダ」・・・
【いただきま~す!】
上学ニュース
本日行われた、給食試食会の様子です。
【学校栄養職員:給食に関する講話】
この後、試食はもちろんですが、児童の配膳の様子、食べる様子も参観していただきました。
出していただいた意見等については、今後の学校給食の参考にさせていただきます。
お忙しい中、来校していただき誠にありがとうございました。
~この後、本日行われた「職業講話」(中学部)の様子をお届けします!~
県中体連選手激励会(7/14)

7月14日(木)、今週末から始まる「宮崎県中学校総合体育大会」に向け、「選手激励会」が開かれました。
出場する部活動は・・・
【男子剣道部】
【女子バレーボール部】
【野球部】
【県大会での抱負(各主将より):全国大会出場目指して頑張ります!】
【選手宣誓】
選手の皆さん、それぞれの目標に向かって、悔いの残らないように、全力でプレーしてきてください!
GO FOR IT!!DO YOUR BEST!!
今日の給食&上学ニュース!(7/13)
【今日のメニュー】
〇チーズパン、牛乳
〇豆のスープ
〇いんげんのソテー
給食のパンは、佐土原町のパン工場で作られています。朝早い、まだ暗いうちから作り始めるのだそうです。その他にも、お米屋さん、牛乳屋さん、野菜屋さん、肉屋さん、それから調理員さん・・・、たくさんの人たちが関わって給食はできあがります。
世界には、食べ物が足りなくて困っている国がたくさんあります。
感謝していただきましょう!
【上学ニュース!】
7月13日(水)5校時、中学部で行われていたのは・・・
【レベコンです!】
生徒一人一人の学力アップを目指し取り組んでいる、本年度2回目の「レベルアップコンテスト」
【カリカリカリ・・・、えんぴつの音だけしか聞こえない。1教科1教科に全集中】
見事100点の生徒は、お昼の放送で紹介されます!
地域学習出前授業(6年生)
7月12日(火)に行われた、小学部6年生「地域学習出前授業」の様子をお伝えします。
愛するふるさと上新田について調べてきている6年生。今回は、子ども達の疑問に答えてくれる頼もしいゲストの方に来ていただきました。
〇こゆ財団の中山様
〇学校支援ボランティアの岩切様
〇松浦牧場の松浦様
〇宮大生(本校卒業生)の遠藤様
上新田をよく知り、愛し、誇りに思っていらっしゃる皆様です。
【講師の先生に聞いてみたいことをペアで話し合い、確認し・・・】
【積極的に様々な質問をぶつけていきます。】
【一つ一つの質問に丁寧に、そして即座に答えていただきました。(新しい情報もたくさんいただきました。)】
上新田愛あふれる講師の方々のお話を聞き、もっともっとふるさとに対する思いが強くなった6年生でした。
お忙しい中、来校していただき、誠にありがとうございました。
【出前授業後、新しく知った情報をタブレットに入力していく6年生】
上学ギャラリー(7/12)
上学ギャラリーです。
まずは小学部6年生「感じて、考えて、マイネームアート」
マイネームアートということは、作品の中に・・・
【作者の名前が隠れています!分かりますか???】
【分かりますか???】
【分かりませんね・・。今度作者に聞いてみます。それにしても、どの作品もカラフルな色使いの素敵な作品ばかりです。】
続いて、小学部4年生の壁新聞。
【かがやき新聞】
【写真を使ったり、題字を工夫したり、つい読みたくなるような構成になっていました。もちろん内容もGOOD!】
最後に・・・
【中学部2年生の教室にお邪魔しました!きれいなひまわりがたくさん!】
【2Aのいいとこひまわり!?花びらをよ~~く見てみると・・・】
【2Aのいいところは・・・。】
・「明るいところ。一度決めたことはやり遂げるところ」
・「個性豊かで、面白く、楽しいクラス」etc
【友達へのメッセージも・・・。】
・「〇〇君へ いつも私の話をたくさん聞いてくれてありがとう」
・「〇〇さんへ いつも私が話をしているときに、笑顔で聞いてくれてありがとう!私は、〇〇さんの笑顔が大好きです」
じ~~~~ん。
このひまわりを見ただけで、2年生の温かな学年の様子が伝わってきます。
~上学ギャラリー「つづく」~
今日の給食(7/12)
今日は、富田小学校6年生の・・・
リクエスト献立です!
【具だくさんみそ汁】
【鶏の唐揚げ。そしてデザートには・・・】
【チョコクレープ!】
富田小学校6年生のみなさんに感謝しながら・・・
【いただきま~す!!】
ココロを満タンに!(7/12)
7月12日(火)、子ども達が(教師も)楽しみに待っていた、朝の読み聞かせが行われました。
今回から、ボランティア「赤ずきん」の皆様に加えて、保護者の読み聞かせ委員の方にも来ていただきました。
【中学生も絵本の世界に入り込んでいました。】
【今回読んでいただいた絵本の一部です。】
絵本の読み聞かせの効果については、先週、ホームページでも紹介しましたが、今回の読み聞かせでも、子ども達の心にたくさんの栄養を注いでいただきました。
お忙しい朝にもかかわらず、来校していただいた皆様、誠にありがとうございました。
次回は、9月20日(火)です。上学みんな楽しみにしています。
授業の様子
授業の様子をお届けします。
小学部5年生、総合的な学習の時間より・・・。
子ども達が楽しそうに取り組んでいるのは・・・
SDGsすごろく!
遊び感覚で、楽しみながらSDGsについての理解を深めていました。
小学部6年生は・・・
【レッドリボン運動について】
エイズに関する正しい知識や相手を思いやる心について理解を深めることができました。
中学部3年生理科「酸・アルカリと塩」
生徒が、一生懸命顕微鏡のピントを合わせて眺めているものは、塩酸(強酸)と水酸化ナトリウム水溶液(強アルカリ)を混ぜて発生した・・・
塩化ナトリウムの結晶!(塩)きれいですねぇ~!
*中和についての学習でした。
~つづく~
今日の給食(7/11)
【今日のメニュー】
〇 ホットドッグ、牛乳
〇 シーフードチャウダー
今日は、ホットドッグです。
ホットドッグはアメリカの代表的な食べ物です。昔、アメリカに移り住んだドイツ人が、温めたソーセージを売り歩いたときに、そのまま手で持つと熱いため、パンにはさんで販売したのが始まりだそうですよ。
それでは、パンにキャベツとウインナーをはさんで、ケチャップをかけ、思いっきり口を大きく開けて・・・
【いただきま~す!】
新聞掲載のお知らせ(7/9)
7月9日(土)付、宮日こども新聞「学園俳壇」コーナーに、小学部6年生、中武 旺雅さんの作品が掲載されました。
おめでとうございます!
【掲載博品】
「青空に野球のボールが消えていく」
授業の様子(7/8)
授業の様子です!
【小学部1年生「カラフル色水」】
めあては、「えのぐをまぜて、いろいろな色をつくろう」
なにか、すごく楽しい時間になりそうな予感が・・・
【ゴクゴク飲みたいくらいのきれいな色だね!】
【あ~ら、でっかいきれいなお耳!】
目を輝かせながら、色の変化を楽しんだ1年生でした。
【中学部1年生音楽♫】
めあて「正しい音程、リズムで歌うことができる」
【「ふるさと」を頭声的発声のとても美しい声で歌っていました。情景がうかんでくるようでした
】
最後に理科は感動だ!中学部3年生「水溶液の性質」です。
【家庭科室で調理???理科なのに・・・】
【紫キャベツを炒めて・・・。とってもカラフルですねぇ】
【焼きそばを投入すると・・・】
【あ~ら不思議!徐々に麺が緑色に変身!】
焼きそばに含まれるかんすい(アルカリ性)が紫キャベツの成分と反応して色が変わったのです。
紫キャベツには、いわゆるリトマス試験紙のようなはたらきがあるのです!ちなみに、レモン(酸性)を入れるとピンクに変わります!
おもしろいですねぇ!やはり「理科は感動!」です!
今週もたくさんのドラマが生まれた上学です。
それではみなさん・・・
【また来週お会いしましょう!(1年生初めての大プールより・・)】
人権集会(7/8)
7月8日(金)、今年度1回目の人権集会が開かれました。
【人権委員会が進めていきます。】
【上新田学園の実態:心のアンケートより・・・】
【友達をたくさん作る魔法の言葉・・・「ありがとう」「ごめんなさい」】
【「命」に関する絵本の朗読・・・。静まりかえる会場・・・。いじめ、命、について深く考えさせられる内容でした】
本校の人権意識の現状と課題を共有し、さらに上学が温かい、居心地のいい学校へと成長していくための貴重な集会となりました。
人権委員会の皆さん・・・
【ありがとうございました!】
今日の給食&上学ギャラリー(7/8)
【今日のメニュー】
〇麦ご飯、牛乳
〇ゴーヤチャンプルー
〇ささみときゅうりのごま和え

今日は、沖縄の郷土料理・・・
【ゴーヤチャンプルーです!】
「チャンプルー」とは、沖縄の方言で「混ぜる」という意味だそうです。
【ゴーヤチャンプルーをご飯にチャンプルー】
【もうひとふんばりの金曜日、ゴーヤを食べて元気いっぱい頑張りましょうね!】
上学ギャラリー
いつも、季節を感じさせる花が飾られている中学部3年生教室です。
この日は、美しいグラジオラスが飾られていました。きっと毎日生徒達の心を癒やしてくれているのでしょう。
それでは、癒やし効果も期待できる!?上学ギャラリーをご覧ください。
【1年生ギャラリーより・・・】
【タイトル「にじいろの空とぶユニコーン」】
【タイトル「海のパーティ」】
【タイトル「ぞうとりんごのむら」】
【タイトル「りんごがすきなキリンの親子」】
タイトルにも癒やされますね!
続いて図書館・・・
【読書感想文・感想画「課題図書コーナー」。ぜひ、夏休みに読んで、取り組んでみましょう!】
最後に・・・
【中学部1年生学級目標「最協団結」(みんな仲良し!中学部1年生らしい目標です!)】
情報モラル教室(7/7)
7月7日(木)、小学部5、6年生、中学部を対象にした「情報モラル教室」を開催いたしました。
【まずは、児童生徒会長と「上学宣言」確認のための読み合わせ】
その後、講演会(教室)へと入っていきました。
目標は「インターネットやスマホ、SNS等の正しい使用法を身に付ける」ことです。
【講師は、「一般社団法人 共生と共育ネットワーク」の青山様】
【子ども達は、どんな情報時代を生きているのか?】
これからの情報時代を生きるために必要なキーワードは・・・
【デジタルシティズンシップ】
デジタル世界を生きる一人の人として、どのように振る舞うことがよいことなのか考えること。つまり・・
「リスクを最小化し、チャンスを最大化する!」
【真剣に話を聞く子ども達】
もっともっと話を聞きたいと思うほど興味深い話ばかりでした。子ども達にとって、とても貴重な機会となりました。
お忙しい中来校いただいた青山様、誠にありがとうございました。
今日の給食&上学ニュース!(7/7)

今日は、もちろん七夕にちなんだメニューです。
【まずは、魚そうめん汁】
【そうめんで天の川を・・・】
【輪切りのオクラで星をイメージしています!なるほど~!】
そして、もちろん・・・
【たなばたぜり~~~~!いただきま~す!】
星に願いを・・・②(7/7)
前回の小学部1年生「七夕飾り制作」につづく、「星に願いを・・」PART2!
いよいよ今日は、7月7日(木)七夕です!
織り姫と彦星は、1年ぶりに運命の再会を果たすことができるのでしょうか。夜、星空を見上げるのを楽しみにしています。
小学部4年生の理科では・・・、
この日を選んだかのように「夏の星空」の勉強です。
【先生から送られてきた鮮やかな「夏の夜空」の画像から・・・】
【「夏の大三角」を見つけていきます。ポイントは、明るさと大きさです。さぁ4年生、見つけ出すことができたのでしょうか?】
【お見事!3つの星、こと座のベガ(織り姫)、わし座のアルタイル(ひこ星)、はくちょう座のデネブ(織り姫の父)を見つけ、線で結ぶことができました。】
4年生が今夜、目をきらきら輝かせながら、きらきら星を眺めている姿が目に浮かぶようです。
学習したことを生活に活かし、より豊かに日常を過ごすことができる・・・。理科という教科の最大の魅力です!
「星に願いを・・・」、この後給食に「七夕ゼリー」が出ます!
乞うご期待!
今日の給食&上学ニュース!(7/6)
給食の時間ですが、時を戻して・・・
【中学部1年、朝の活動の様子。「7月6日。今日は何の日???」】
この味が いいねと君が 言ったから
7月6日は サラダ記念日
俵 万智
ということで今日の給食は・・・
【サラダにスポットライト!エッグサラダです!】
夏バテ防止のためにもバランスのよい食事を心がけましょう!
【今日のメニュー】
〇コッペパン、牛乳
〇鶏肉とマカロニの煮込み
〇エッグサラダ
上学ニュース!
【中学部2年生、家庭科「調理実習」】
【作っているのは・・・】
【しょうが焼きです!写真からいい匂いが漂ってくるようです!では実食!】
【この味が いいねと 君が言ったから 7月6日は・・】
【しょうが焼き記念日!】
読み聞かせ講習会(7/5)
7月5日(火)、PTA教育部、読み聞かせ委員の方を対象にした「読み聞かせ講習会」が行われました。
講師は・・・
【読み聞かせボランティア「赤ずきん」の皆様です。】
【夜遅くでしたが、読み聞かせに情熱を燃やす!11名の方に参加していただきました。】
【絵本の持ち方や見せ方、読み方・・】
【紙芝居の効果・・・】
【選書の仕方や読み聞かせの楽しさなど多くのことを伝えていただきました。】
1時間という時間が短く感じるくらい、保護者同士も積極的に意見を交わし合う、充実した時間となりました。
これから読み聞かせをするに当たって、とても参考になる講習会になったと思います。
「赤ずきん」の皆様、お忙しい中来校いただき、誠にありがとうございました。
最後に・・・
読み聞かせには様々な効果があると言われています。
①子どもの精神状態を落ち着かせる。
②子どもの心にいろいろな「栄養」を与えてくれる。
③子どもが自主的に他者とのコミュニケーションを学べる。
④子どもの好奇心を高められる。
⑤親子の絆が深いところで結ばれる。
学校では、これから月に1度行われますが、ご家庭でも絵本の読み聞かせに積極的に取り組まれてはいかがでしょうか。
【昨年度の読み聞かせの様子より・・・】
理科は感動だ!(7/5)
7月5日(火)、理科は感動だ!中学部1年生の様子です。
学習問題「発生した気体は何だろう?」
まずは・・・
【酸素系漂白剤+60℃のお湯では?集めた気体に線香の火を入れてみよう!】
【マッチを使って、線香に火を・・・。おっかなびっくりの子もいましたが、この子は、実にスムーズに火をつけることができていました。】
それでは、線香投入!
【激しく燃えました!酸素が発生したもようです!】
続いて混ぜるものは・・・
【白い物体を持つ少年。それはなぁに?】
【だ、だ、だ、大根おろし!おいしそう・・・.ご飯にかけるわけではないよね?!】
【組み合わせは、大根おろしとオキシドール(過酸化水素水)です!みなさん、どんな気体が発生したと思いますか?正解は・・・】
【またしても激しく燃え上がる線香の火。酸素が発生したのです!】
身近なものを使って、酸素が発生することに生徒はびっくり!
今日も、科学の楽しさを実感することができました。
~つづく~
今日の給食&上学ニュース!(7/5)
【今日のメニュー】
〇ひむか丼、牛乳
〇冬瓜スープ
今日の給食は、にんじん、千切り大根、えのき、しいたけ、青ピーマン、赤ピーマンなど、宮崎特産の野菜がたっぷり入った・・・
【ひむか丼です!汁が具材にたっぷりしみこんでいて、とてもおいしかったです。】
上学ギャラリー
7月に入り・・・
【図書館の掲示物もリニューアルです!今回のテーマはもちろん・・】
【七夕ですね!お星様がきらきら輝いています!その他にも・・】
【かき氷屋(本)さん!昼休み、本を借りた人にはもれなく・・・】
【かき氷のしおりをプレゼント!(私は抹茶あずきがいいなぁ!)】
SUMMER CONCERT IN KAMIGAKU(7/5)
7月5日(火)朝、体育館に素敵な音色が響きました。
ハンドベルクラブによる「サマーコンサート」です。
【司会は、文化広報委員会。よく通る声でスムーズに進めてくれました。】
【今年度のファーストコンサートです。ちょっと緊張気味の子ども達。1曲目は・・】
【トゥインクル トゥインクル リトルスター】
【指揮に合わせて素晴らしい演奏が続きます・・・。】
【2曲目「アメリカ」】
【3曲目「たなばたさま」】
3曲とも有名な曲ですが、ハンドベルの音色は癒やし効果があるようです。うっとり聞きほれてしまいました。
【子ども達もうっとり・・・】
【保護者の方々もうっとり・・・】
【進んで感想を言ってくれる子ども達】
【保護者の方も・・・。「朝から素敵な音楽を聞いて、今日1日、気持ちよく過ごせそうです。」】
外は、台風通過中。気分も少し雨模様だったのですが、ハンドベルクラブのみなさんの息の合った演奏を聞いて、心はすっきり青空へと変わりました。
みんなに幸せを運ぶコンサートを開いてくれて、ありがとうございました!
台風4号の接近に伴う対応について
7月5日(火)の対応について
〇 通常通り授業を行います。(給食あり)
河川や用水路の水かさが増しています。安全に注意して登校させてください。
今日の給食&上学ニュース!(7/4)
【今日のメニュー】
〇黒糖パン、牛乳
〇塩ラーメン
〇揚げ春巻き
今日のおかずは・・
【外はパリッパリ、中はジューシーな揚げ春巻きに(大豆油で揚げています)・・・】
【子ども達のオスス麺、塩ラーメン!それではみなさん、ご一緒に・・】
【サ○〇〇一番、塩ラーメン!♫】
上学ニュース!
台風4号が接近中です。(明日最接近し、九州に上陸する可能性もあります。)996ヘクトパスカルとそれほど大きな台風ではないようですが、瞬間最大風速は、25mと予測されています。
「備えあれば憂い無し」早め早めの対応を心がけましょう!
*本日、「台風4号の接近に伴う学校の対応」について文書を配付しました。ご確認ください。
【アサガオとミニトマト、避難完了!】
授業の様子(7/4)
夏休みまでのカウントダウンも、残り12日となりました(子ども達が登校する日)
これから1学期のまとめに入ります。学習内容が定着できるように、今後しっかり取り組ませていきます。あわせて、家庭学習での取組、見届けもよろしくお願いします。
それでは、授業の様子です。
4年生社会「ゴミの分別と再利用」の学習の様子です。授業の後半部分を参観させていただきました。
【この時間の学習内容の定着を図るため、デジタルドリルに取り組んでいました。】
【「ピンポ~~ン!」楽しみながら理解を深めていました。】
3年生、外国語活動「好きな色を伝えよう」の学習です。
【次々とペアを変えて練習中。分からないときは先生が優しく教えてくれます。】
【「What's collar do You like?」「I like pink.」(ジェスチャーも交えながら表現)】
続いては・・・
【アダム先生(ALT)の言う色を並べていくカードゲーム!「できた人?」】
【「はぁ~~い!!」お見事!】
どんな勉強でもがんばる3年生ですが、特に外国語活動では、よりアクティブに学習しています!
先週金曜日、全校で1番最後にプールに入った中学部2年生。
待たされたぶん・・・
【思いっきり泳ぎます!1年ぶりなのに見事なクロールです!】
【うれしすぎて、飛ぶように走ります!(本当に水上を走っているみたい・・)】
以上授業の様子でした!それではみなさん・・・、
【よい1日を~~!】
*台風4号が近づいています。大雨に、じゅうぶんお気を付けください。
星に願いを・・・(7/1)
今日は、小学部1年生がとっても楽しみにしていた
【「七夕交流会」が行われました!】
【今年も「更生保護女性会」のみなさんに来ていただき、七夕飾り作りのお手伝いをしていただきました。】
まずは、七夕気分を盛り上げるために・・・
【「たなばたさま」をみんなで歌いました。】
【「ささのは さーらさら のきばにゆれる・・・♫」】
【それでは、飾り作りスタート!です。】
【教えていただきながら、素敵な飾りが続々と完成!】
【スイカとたこ!(なぜかたこが1番人気でした!)】
*撮影時のみマスクを外しています。
それでは、みんなで・・・
【短冊や飾りを笹の葉に結びつけていきます】
【ぼくの願いが叶いますように・・・。】
さて、1年生は、どんな願い事をしたのでしょうか?

【「動物園の飼育員さんになれますように」「ケーキ屋さんになれますように」】
【最後に、七夕飾りをバックに、みんなで記念撮影!】
更生保護女性会のみなさま、1年生にとって、素敵な思い出が一つ増えました。ありがとうございました。
今日の給食&上学ニュース!(7/1)
【今日のメニュー】
〇麦ご飯、牛乳
〇鮭の塩焼きたくあん和え
〇どさんこ汁
7月最初の給食は・・・
【鮭に・・・】
【「どさんこ汁」と、まさに、夏の北海道祭り!】
「どさんこ汁」には、じゃがいも、たまねぎ、にんじん、とうもろこしなど北海道でよくとれる食材が満載です。また、みそ汁にバターが入っていて、とっても濃厚でおいしかったです。
上学ニュース!
昼休みの体育館、ハンドベルの素敵な音色が聞こえてきました。
来週火曜日に行われる「サマーコンサート」のリハーサル中でした。
当日は3曲も演奏するそうです。とっても楽しみにしています!
小さな旅⑧(7/1)
今日から7月です!
夏真っ盛りの上学を歩く「小さな旅」をお届けします。
【上学の玄関にも・・・】
【夏が来ました!かわいいミニひまわりに・・・】
【立ち止まって眺める子ども達・・・。小さくても、思いっきり黄色い花びらを広げるひまわりに元気をもらいました。】
【朝の小学部3年生教室。何をしているのでしょう・・・】
【ストレッチ中・・・。体が柔らかいですねぇ~!】
【握力を鍛える「グーパー体操」。体力向上に向け、毎日続けている、朝の光景です。】
昼休み、この暑さの中・・・
【元気にサッカー!熱中症防止対策で、途中放送が流れ、全員水分補給を行います。】
そんな中、こんな暑い日はと・・・
【日陰で、お絵かきにいそしむ子ども達・・・。かいている姿はどこかの有名画伯!何をかいているの?運動場を描いた風景画かな?】
【まさかの人物画!お母さんをかいたそうです。あなたにそっくりですね!隣の少年はというと・・・】
【きょとうせんせい!?私をイケメンに描いてくれました!ありがとうね!】
最後に、7月もみなさんに・・・
【たくさん幸せが訪れますように・・・。(タイトル「四つ葉のクローバーを発見したラッキー少女」】
「小さな旅」PART8~おしまい~
福祉体験学習(中学部3年生)
6月30日(木)、中学部3年生、福祉体験学習「認知症サポーター養成講座」の様子をお届けします。
講師に新富町包括センター、新富町社会福祉協議会の方々に来ていただきました。
まずは・・・
【認知症について知ることからです。】
【↑認知症の方への声のかけ方についても、寸劇で楽しく、分かりやすく説明していただきました。】
今後の接し方については・・・
【生徒達の優しい思いが伝わってきますね・・・。】
そして、最後に・・・
【生徒みんなでアクティビティ!(コミュニケーション図る楽しいゲーム)】
【握手して・・・】
【肩を組んで仲良しこよし・・・。】
【元気に「おー!」】
緊張気味だった生徒達の・・・
【心と体を解き放ちました!】
現代社会における認知症について理解を深め、多様な社会を生き抜くための力を育てる貴重な体験学習となりました。
お忙しい中、来校いただいた講師の皆様、誠にありがとうございました。
天災は忘れた頃に・・・(6/30)
6月30日(木)、地震津波想定避難訓練を行いました。
【避難指示が出てから、迅速に避難する子ども達。避難の合言葉は・・・】
【お・は・し・もです。(押さない、走らない、しゃべらない、もどらない)しっかりできました!】
前回の訓練では、全員避難するまでにかかった時間は、3分ちょうどでしたが、今回は・・・
【2分50秒!「その1秒が命を守る」と言われていますが、10秒も早く避難することができました。】
その後、熱中症防止対策から・・・
【教室に戻り、放送にて担当職員の話を聞きます。】
【先日発生した熊本地震について・・・。そして、40年以内に90%の確率で起こるとされる南海トラフ大地震について・・・】
【真剣に話を聞く子ども達】
【校長先生の話:「天災は忘れた頃にやってくる」ただ、地震はいつ起こるか分からない。6年前の熊本地震では・・・】
【事後指導。小学部1年生の様子】
【地震発生時のニュース速報を視聴。緊急アラートが鳴り響いています。】
【実際に身を守る方法を学習】
【完璧です!】
「自分の命は自分で守る」ために、しっかり訓練に取り組んでいた子ども達(先生達)でした。
今日の給食&上学ニュース!(6/30)
【今日のメニュー】
〇麦ご飯、牛乳
〇タコライス
〇もずくスープ
今日の給食はタコライスです!タコと言っても海にいるタコでも、お正月に揚げるタコでもないですよ!
メキシコのタコスという料理の具をご飯にのせて食べることからタコライスと呼ばれています。
今日は、ご飯の上に具をのせて・・・
【いただきま~す!】
上学ニュース!
明日から7月です。7月といえば・・・
七夕ですね!早速、5,6年教室前に掲示してありました。
【願い事叶うといいね!】
そして、明日は・・・
小学部1年生の「七夕飾り制作」があります。(昨年度の様子です。)
【準備万端整いました!明日をとっても楽しみにしている1年生です!】
夏だ!プールだ!初泳ぎ!②(中学部編)
中学部のみなさん、お待たせしました!
小学部から遅れること1週間。いよいよ「夏だ!プールだ!初泳ぎ!」です。
中学部1年生と3年生の様子をダイジェストでお届けします。
【どんな汚れも弾き飛ばす?!強烈シャワー!小学部同様、歓声と悲鳴が響きます・・・】
【中学生も大好き!流れるプール!】
【中学部3年生、「宝探しゲーム」!誰が1番お宝を見つけられたかな?】
【WINNER!】
続いては、生徒の様々な泳ぎ(技)をご堪能ください。
【クロール!(中1)】
【バタフライ!(中3)すご~~い!】
【美しい背泳ぎ・・・】
【シンクロナイズトスイミング ソロ?(アーティスティックスイミング)】
【シンクロナイズトスイミング デュエット?】
【クラゲ・・・?】
1年ぶりのプールを思いっきり楽しんでいた生徒達でした。
~おーしまい!~
今日の給食(6/29)
6年生、朝の活動の時間。あるアンケートに答えていました。
【好きな給食アンケート】
不動の人気NO.1パンは、「揚げパン」なのですが、NO.2は・・・、
【米粉パンです!】
そして、子ども達の願いが通じたのか、今日のメニューは・・・
〇米粉パン、牛乳
〇かぼちゃのポタージュ
〇アーモンド和え
KOMEKOファンクラブの子ども達は、そりゃもう大喜び?!
【もっちもちの食感が最高です!】
【そのままかぶりつくワイルドな少年!】
【ぼくは、かぼちゃポタージュに浸して、いただきまーす!】
明日は、6月最後の給食!「タコライス」を楽しみにしていまーす!
今日の給食&上学ニュース!(6/28)
【今日のメニュー】
〇麦ご飯、牛乳
〇コロッケ、キャベツのレモン和え
〇けんちん汁
中学部生徒のみなさん、定期テスト・・・
【お疲れ様でした~!】
【プレッシャーから解放された今日の給食は・・・】
【さぞ、おいしいことでしょう!】
(番外編)
今日の小さいおかず・・
【コロッケをめぐる熱い戦いをご覧ください!】
【残ったコロッケをめぐる「じゃんけん大会!」・・・。運命の結果は???】
【WINNER!た~んとお食べ!】
授業の様子
つい最近、ホームページで梅雨入りのニュースをお伝えしましたが、あっという間に梅雨明けが発表されましたね。
これから暑い日が続きそうですが、熱中症対策、コロナ対策両立させながら、取り組んでいきたいと思います。
では、授業の様子をお届けします。
【小学部3年生図工「多色版画」の様子です。ローラーでコロコロ・・】
【馬楝でゴシゴシ・・・】
【素敵な仕上がり!この後色づけしていくそうです。完成を楽しみにしています。】
【4年生体育「体つくり運動」、体育館には様々な体力づくりの場が設定されています。】
【腹筋コーナー!(私の耳にロッキーのテーマ曲♫が流れてきました。)】
【ドリブルコーナー】
【跳び箱コーナー。見事な跳躍です!】
【平均台を使って・・・。「せ~~の!」】
【2人息を合わせてジャ~~ンプ!】
暑い中でしたが、意欲的に体力づくりにチャレンジしていました。
最後に・・・
【6年生「習字」の学習中】
【みんな心を落ち着かせて、一筆一筆心を込めて!】
【ある少年の渾身の力作!さぁ、学校名と名前を・・・。あれっ?!何か違和感・・】
【止める・・・?止新田小?頭を抱えてしまった少年でした。ドンマイ!また、書けばいいよ!】
~おしまい!~
上学ギャラリー(6/27)
久しぶりの上学ギャラリーです!(本当は、参観日でじっくり見ていただきたかったのですが・・・)
【5年生「言葉の広場」コーナー:NIEに取り組んでいます。】
*NIEとは、新聞を教材として活用し、興味や関心の幅を広げる教育のことです。newspaper in education(教育に新聞を)
【3年生「わたしたちの上新田」:自分たちの足を使って調べた地図が完成です!】
【6年生教室にて・・・】
【SDGsコーナー】
【小学部2年生掲示板】
【タイトル「ゆけ!ブルーインパルス」】
【低学年が今、休み時間のたびに取り組んでいるのが・・・】
【世界の国旗や日本地図パズル。遊びながらどんどん国名や県名を覚えています。】
~つづく~
今日の給食&上学ニュース!(6/27)
【今日のメニュー】
〇減量コッペパン、牛乳
〇焼きそば
〇杏仁フルーツ
今日は、焼きそばに入っている・・・
「竹輪」クイズです!
竹輪はいったい何から作られているでしょう?
①小麦粉 ②豆腐 ③魚
さて何番でしょう?答えは、お昼の放送で流れ、子ども達が知っているのでお聞きください。(さぁ、しっかり聞いていたかな?)
【上学ニュース!】
今日と明日、中学部は・・・
【定期テストです!(中学部2年生教室)】
【中学部1年生「めあて」より・・・】
日頃の授業態度、家庭学習の取組の成果が試されます。
【最後の一問まで、粘り強く、全力で頑張ってください!】
新聞掲載のお知らせ(6/25)
6月25日(土)付、宮日こども新聞に2名の児童の作品が掲載されました。(2人ともトップ掲載!)
おめでとうございます!!
〇 学園詩壇掲載(中馬宣明選)
小学6年生 藤田 蓮さん 題名「自然」
【評】藤田さん、心が安らぐ魅力的な発想、素敵ですね。動物や虫のあいさつ素敵だなぁ。元気や勇気をもらっているかもしれないよね。童話の世界にいるみたいで夢があるな。
〇 学園俳壇掲載(服部秀一選)
小学4年生 池田 拓斗さん
「もうすこし一人前のトマトの実」
【評】少し青みのあるトマトを巧みに表現。一人前の量のことともとれて面白い。
ようこそ!ふるさと先生!
6月24日(金)、メールでもお伝えしましたが(保護者の方々には)、上新田学園小学部5年生に素敵なゲスト、ふるさと先生が来てくれました。
【新緑園の黒木信吾様です。】
【テレビカメラに大喜びの子ども達】
詳しい授業の様子は、この後、テレビのニュースで報道されますので、ぜひ、ご覧になってください。
【UMKテレビ】
18:09からのニュース
【MRTテレビ】
16:50からのニュース
*18:15からのニュースでも報道されるかもしれません。
小さな旅⑦(6/24)
「小さな旅」、PART7をお届けします。
朝、上学を旅していると・・・
【5年生が、バケツ稲の観察、お世話をしていました。】
【ねぇ、どのくらい大きくなった???】
【Before:5月27日(金)】
【After:約3週間でここまで成長!(この生命力、たくましさあやかりたい!)】
同じ日の朝、楽しそうに歌う声が聞こえてきたので行ってみると
【小学部3年生が元気に「朝の歌」を歌っていました。】
【ノリノリで歌いながら踊る少年発見!いい笑顔です!】
【中学部3年生、朝の活動の時間】
【真剣な眼差しの先にあるものは・・・】
【沖縄全戦没者追悼式の様子です。この少女の平和への訴え、心に響き、目頭が熱くなりました。】
同じく中学部3年生、生徒達の訴えを聞いて、非常階段をのぞいてみると・・・
【白いぞうきんの上、何かうごめく物体が・・・】
【かわいいスズメさん・・・。ガラスに激突して、動けなくなっているところを、ある少年(中3)に助けられたのだそうです。】
生徒達の優しい心遣いで敷かれた白いぞうきんの上で、ゆっくり休んだ後、無事、飛び立っていきましたとさ・・・。めでたし、めでたし。
~おーしまい!~
今日の給食&上学ニュース!(6/24)
【今日のメニュー】
〇麦ご飯、牛乳
〇ビビンバ
〇わかめスープ
今日の小さいおかずは・・・
【ビビンバ!】
「ビビンバ」は、ご存じ韓国料理です。「ビビム」が混ぜる、「バ」がご飯という意味です。ということで・・・

【ご飯に混ぜていただきます!】
上学ニュース!
小学部廊下がリニューアル。(昨日小学部の先生が一生懸命作業をしていました。)
青い線に矢印。もうお分かりですね。
最近少し乱れていた、「右側、一列、静かに」(略すると「右一静歩」)の廊下歩行を意識づけるための取組です。学校内の廊下歩行ができないのに、外に出て、交通ルールを守れるわけがありません。大きな事故にもつながります。

まだ1日目ですが、効果は絶大!「右一静歩」しっかりできていました。
はじめてのプール(6/23)
小学部1年生、「はじめてのプール」の様子です。
【まずは、教室で、「プールのきまり」について大切なお話を聞きます。】
【早くプールに行きたくて、ウズウズ・・ウズウズ・・】
それではレッツゴープール!
【こんなに大きいシャワールームは初めてかな?】
【頭もしっかりゴシゴシしてね!】
しかし、この後、運命のいたずらか・・・
【こんなに天気がよかったのに・・・(5、6年生プール開きより)】
【空からもすごいシャワーが・・・】
幸いこの後、少し小ぶりになったので・・・
【ちょっと寒いけど、初めてのプール入水!歓声(悲鳴?)がひびきわたりました。そして、今日のメインイベント!1番子ども達の笑顔がはじけたのが・・】
【じゃんけん列車!】
【「さいしょーはぐー!じゃんけん・・・」】
【ぽん!】
大雨の影響で、少ししか入れなかったけど、満足した様子の1年生でした。
また明日、プールの授業がありますよ!楽しみにしていてね!
【ありがとうございました!】
本日、5、6年生の水泳の監視のお手伝いを学校支援ボランティアの方(保護者)にしていただきました。おかげで担任の負担が減ると共に、安全面からも大変助かりました。
ありがとうございました!
今日の給食&上学ニュース!(6/23)
【今日のメニュー】
〇麦ご飯、牛乳
〇八宝菜
〇蒸しシューマイ
今日は、チャイニーズデー!
早速ですが、今日の給食に登場している「焼売」。さてなんと読むでしょう?
正解は・・・
【シューマイです!】
小学部2年生教室にて・・・
【シュウマイ!!実は、今日はぼくの誕生日です!!そして、なんと・・・】
【私も誕生日で~す!2人とも・・・】
HAPPY BIRTHDAY!
そして、同じ6月23日なのですが・・・
【上学ニュース!】
児童生徒会長の一言より。
【「今日は、沖縄慰霊の日です。1945年の6月23日に沖縄戦が終了しました・・・」】
世界平和が1日も早く実現しますように・・・。
話は変わります。
中学部3年生は今日・・・
【実力テストに全集中!】
【一人一人、その名の通り実力が発揮できますように・・・。】
中学部1年生社会科の時間は・・
【来週月曜日から始まる初めての定期テストに向けて勉強中・・・】
【教え合い、高め合う姿も見られていました。】
夏だ!プールだ!初泳ぎ!
6月22日(水)、またこの季節がやってきました!
延期になっていた小学部・・・、
プール開きです!一番風呂ならぬ一番プールの幸運を手に入れたのは2、3、4年生です。
真夏を思わせる太陽の下、輝いた水しぶきと子ども達の笑顔をご覧ください。
【「キャ~~!」シャワーを浴びるだけで子ども達は大興奮!】
【あ~、太陽照りつける今日の良き日に感謝いたします!】
【小学生大好き!流れるプール】
【2年生は、オットセイになりながら流れていきます。】
【最高の笑顔ですね~!】
【ただ、笑いすぎて「ゴボゴボ・・・・」。それでも手を振り続けてくれました。】
【3年生は、初めての大プール!ちょっとまだ怖いかな・・・】
これから1ヶ月にわたり水泳学習が続きます。全身運動ですので運動効果が非常に高いと言われます。ただ、ともすると命に関わる事故を引き起こすこともあります。安全への配慮を最大限行いながら、進めてまいります。
家庭におかれましても、お子さんの体調面への心配り、準備物等の確認をよろしくお願いいたします。
今日の給食&上学ニュース!(6/22)
【今日のメニュー】
〇バーガーパン、牛乳
〇白身魚のフライ、キャベツ、タルタルソーズ
〇コーンスープ
↑この写真を見てもうお分かりでしょう!?
今日は、子ども達が楽しみにしていた・・・
【ハンバーガーです!(我ながらエレガントにはさめました!)】
【私もハンバーガー作ってみました!ね・ん・ど・でね!(間違えて食べてしまいそう・・・】
上学ニュース!
コロナ感染症防止の観点から延期になっていた、保体給食委員会による「歯みがき指導」がスタートしました。
この日は6年生です。
【模型を使って、歯みがきのポイントを分かりやすく説明】
【「あなたはだんだん眠くなる~」ではなく・・・、歯ブラシの交換時期をチェック中】
【反対側から見て、毛先が見えたらアウト!】
これから全学年に「歯みがき指導」を行っていきます。
正しい歯みがきをして、虫歯にならない健康で丈夫な歯を保ちましょう。
家庭でもお子さんの歯みがきをチェックしてみてください。
授業の様子②(6/21)
授業の様子PART2!
3年生学級活動「話そう・聞こう・みんな友達」(人権教育)の様子からです。
【みんな無言で黙々と作業。何をしているのかな?】
【言葉を発せずに、協力して図形を完成させていきます。】
【アイコンタクトやジェスチャーを交え、心を通わせていました。続いては・・】
【すごろくタ~~イム!】
【家での楽しみは???今度は、言葉で伝えていきます。】
【「家族みんなでご飯を食べること!」素敵な家族なんだね!】
【指令「みんなでハイタッチ!」がコロナ感染防止のためできないので、エアタッチ!それでもみんな最高の笑顔です。】
友達のことをよく知るきっかけになりましたね!
中学部1年生美術「版画」の授業です。
【一彫り一彫り魂を込めて・・・。それにしても下絵が上手!みんな安全に気を付けて、集中して取り組んでいました。しかし、集中しすぎて、版画アルアル・・】
【こんなに長くなっちゃいました!】
ではみなさん、また明日、元気にお会いしましょう!
6月21日(火)授業の様子「おしまい」
授業の様子①(6/21)
6月21日(火)、参観日が中止になってしまったので、その分、授業の様子をたーっぷりとお伝えしたいと思います。
まずは、中学部3年生・・・
体育でもコロナ対策です。非接触型スポーツの「バドミントン」「卓球」を行っていました。
【蝶のように舞い、豪快にスマッシュ!】
【ブロック!!珍プレー・好プレーの連続でした!そのころ卓球場では・・・】
【超ミラクル回転サーブを受けてみろ!】
【チョレイ!!(呆然と立ち尽くす少年・・)】
続いては、音楽特集!
【小学部2年生音楽。ようやく鍵盤ハーモニカの練習も解禁です!】
【鍵盤をうれしそうに押さえながら、生の音を楽しんでいました。(これまではタブレットを使ってやっていました)】
*コロナ感染症防止の観点から、対面にならない、全員で音を出さない等の対応をしています。
【リコーダー練習も解禁です。】
【高音で響くリコーダーの音色に癒やされました。】
~まだまだ「つづく」~
今日の給食&上学ニュース!(6/21)
【今日のメニュー】
〇麦ご飯、牛乳
〇うま煮
〇春雨の酢の物
最近の食生活では、気を付けないと食物繊維が不足しがちだと言われています。給食では・・・
野菜や豆製品、海藻などを意識して提供していただいています。(ありがたいことです!)
普段の食事でも積極的に取り入れていくといいですね。
【上学ニュース!】
梅雨本番。今朝は、土砂降りの雨・・・。
【上学恒例?駐車場は車の大渋滞。自転車小屋は何と・・・】
【わずか1台・・・。さびしいですね・・・。(逆にこの1台が輝いて見えます!昔は、よほどのことがない限り、上中生みんなカッパを着て、自転車で通ったものですが・・)】
そんな中・・
【靴をぐっしょり濡らしながらも、元気に登校する子ども達。(教室で靴下を着替えていました。)たくましい上学っ子の姿も見られ少し安心しました!】
学校便り「座論梅」6月号
今日の給食&上学ニュース!(6/20)
【今日のメニュー】
〇コッペパン、牛乳
〇チリコンカン
〇千切り大根のゴマネーズサラダ

チリコンカンは、アメリカテキサス州が発祥(諸説あり)と言われています。もともとはピリッとした辛さの料理ですが、給食では優しい味にしてありました。
【上学ニュース!】
【「学級活動」研究授業の様子より】
6月17日(金)、3週間にわたって行われた教育実習も、いよいよ最終日。
生徒、先生(実習生)、お互いの心に残る1日となりました。
【お別れドッジボール大会!?ルールは、先生(実習生)が当てられたら負け!】
【先生へ一斉攻撃!最終日なのにかわいそうじゃない!】
【安心してください!先生を必死に守る正義の味方登場!!笑顔はじける1時間となりました。】
【午後のホームルーム・・・。お別れ会が開かれていました。涙、涙なのかと思っていたら・・・】
【お笑いコンビ登場!一発芸対決!教室は・・・】
【笑いと拍手の渦に・・・】
【先生も大爆笑!!】
時は流れて、いよいよクライマックス。
【最後のあいさつ】
【生徒達への思いがあふれてきます。】
【生徒からのお礼の言葉や花束贈呈】
【生徒の目にも光るものが・・・。本当に大好きな先生だったんだね!】
最後に・・・
【生徒全員でエールを送ります!「フレ~~~!フレ~~~!」】
いつも笑顔で積極的に生徒に話しかけている姿が印象的でした。授業も、実習生とは思えないほど、落ち着いていて、生徒の心に届くように、一言一言話していました。
短い期間でしたが、きっと生徒の心にいつまでも残る素敵な先生となったことでしょう。
いつか、教師として学校現場に戻ってきてくれることを心から願っています。
3週間、本当にお疲れ様でした!
小さな旅⑥(6/17)
「小さな旅」PART6。忙しい毎日、ほっと心穏やかになる一時をお過ごしください。
まずは、朝、たくさんの荷物を持っている少年発見。何かイベントがあるのかと尋ねてみると・・・
【足をけがして、松葉杖をついている友達の荷物を持ってあげているのでした。朝からさわやかな気持ちにさせてもらいました。】
続いては、このコーナー恒例の理科室編
【小学3年生が見つめる先にあるものは・・・】
【羽化したばかりのモンシロチョウ・・・。この後、元気に飛び立っていきましたとさ。めでたし、めでたし・・】
【小学1年生がうれしそうに持ってきたものは・・・】
【昆虫界夏のアイドル、THE クワガタ!黒光りがかっこいいですねぇ】
【昼休み、お花を摘んでいる5年生を発見!】
【ハルジオンの花束を作っていたのですね。この花束を何と私にプレゼント???】
【と思いきや、1年生へ!!(やっぱりね・・)】
【よかったね~!・・・。大事に育てるのですよ!】
最後に、中学部1年生、登校後すぐに・・・
【新聞に投稿する短歌を持ってやってきました。(この生徒はこれまでに何度も宮日に掲載されている上学の才女(歌人)です!)】
手渡され時・・
【登校中に見つけた、かわいい一輪の花が添えてありました。こんな心遣いができる生徒だから、素敵な短歌が生まれるのでしょうね!感動しました!】
~PART7へと「つづく」~
今日の給食&上学ニュース!(6/17)
【今日のメニュー】
〇麦ご飯、牛乳
〇ポークカレー
〇日向夏ドレッシングサラダ
今日の給食は、みんな大好き、テンションMAX・・、
【ポークカレー!】
とってもクリーミーな甘口カレー!ほとんどのクラスで残食0でした!!
【上学ニュース】
ここ最近、小学部は遠足や社会科見学ラッシュです!
今日も4年生が、「エコクリーンみやざき」へと社会科見学に出かけていきました。
昨日は・・・
6年生が「古墳巡り&西都原考古博物館学習」へ・・・。
まずは、ふるさとの宝「百足塚古墳」から・・・
【新富町教育委員会生涯学習課の方に説明していただきました。ありがとうございました!】
【お墓(古墳)の前でハイチーズ!(後ろに何か映っていない?)】
続いて向かったのは・・・
【西都原考古博物館。西都原古墳群の説明を受けた後は・・・】
【館内を見学して回ります。】
【土器に埴輪に勾玉、石室、そして本物の骸骨・・・。今から数千年前にタイムスリップし、古代ロマンを感じることができました。】
そして、たくさん学んだ後は、もう一つのお楽しみ・・・
【お弁当タ~イム!梅雨の中休み、雨が降らなくてよかったねぇ~!】
~おしまい!~
授業の様子(6/17)
もうひとふんばりの金曜日。
授業の様子。4年生「理科は感動だ!」からスタートです。
【子ども達が一生懸命作っているのは???】
【暑いから扇風機???いやいや・・】
【モータープロペラを作って、これから電気のはたらきや特徴について学習していきます。】
続いては・・・
【中学部1年体育「マット運動」】
スゴ技を見せていた少女を発見!
【後転倒立!(その名の通り後転の後倒立)この技ができる生徒を初めて見ました!】
【小学部5年生家庭科の授業。前回の「玉どめ」に続き、今回チャレンジするのは・・・】
【「波ぬい」です!上手にできましたね!】
~つづく~
今日の給食&上学ニュース!(6/16)
【今日のメニュー】
〇麦ご飯、牛乳
〇チンジャオロース
〇五目中華スープ
今日の小さいおかずは、チンジャオロース。「青椒肉絲」と書きます。「肉」はそのままお肉。「絲」は細切りの意味だそうです。
つまり、「食材+食材+切り方」をそのまま並べただけの名前なんですね。あえて日本語で言うと・・・
【「豚肉とピーマンの細切り炒め」!!ご飯がすすむ味付けで、とてもおいしかったです。】
【上学ニュース!】
小学部1年生の「がっこうたんけん」の様子を、以前ホームページでもお伝えしましたが・・・、たんけん大好き1年生、今回は・・・
学校の外へ飛び出します!(道路に飛び出しはダメよ!)
「学校の周りたんけん」です!どんな冒険が待っているのでしょうか!?どんな発見をするのでしょうか!?乞うご期待!
【しゅっぱつしんこ~う!】
【まずは、旧上新田小跡地】
【JA】
【横断歩道は手を上げて・・・。交通安全の練習にもなりますね。】
【なんか楽しそうな場所発見!子ども達の目の色が変わります・・。】
【夢中になって何か探しています。】
【「何をつかまえたの???」赤ちゃんバッタみたいです。その他にも・・・】
【こっちはカエルさん。その他にも・・】
【た~くさん発見できて大満足の子ども達でした!】
最後に、このたんけんにご協力くださった全てのみなさんに感謝の気持ちを込めて・・・
【ありがとうございました!(敬礼!)~こちら上新田派出所前にて~】
次のたんけんも楽しみですね!「おしまい」
みんなでゴシゴシ・・・(プール掃除の巻)
今週2日間かけて、中学部、小学部5、6年生で「プール掃除」を行いました。
まずは、この画像をご覧ください。
【Before:ヘドロ状態・・。ナゾの生物もうごめいています。】
【まずは、中学部の登場です!キャーキャー言いながらも・・・】
【この腰の入ったブラシさばきをご覧ください!】
【雨の中、学校支援ボランティアの方(保護者)も来ていただき、高圧洗浄機でピカピカに磨いてくださいました。】
続いては、大雨で延期になっていた小学部
【小プールを掃除です!】
【見事な連係!横一列の隊列を組み、ゴシゴシ・・。 いい仕事していますね!】
【水は~うち~!ドロは~そと~~!】
そして・・・
【After:夏の陽射しを浴びながら、思いっきりプールを楽しむ子ども達の姿が目に浮かぶようです。】
【昨年度のプール開きより】
*6月20日(月)がプール開きです。
今日の給食(6/15)
【今日のメニュー】
〇減量ミルクパン、牛乳
〇ナポリタンスパゲティ
〇野菜サラダ
今日のパンはミルクパン、そして、パンのお供には牛乳(ミルク)。
牛乳といえば、カルシウム!骨や筋肉を作るたんぱく質も豊富に入っていますね。
わたしの場合、ミルクパンの中に、ナポリタンをはさんで・・・
【ミルクナポリタンパン!(早口で3回言ってみましょう!)】
子ども達みんな、口の周りをナポリタン色?!に染めながらおいしそうに頬張っていました!
栄光をたたえる!(6/15)
6月15日(水)、児童生徒集会を行いました。
今回は・・・
先日行われた中体連の表彰式です。
本来ならば、全校児童生徒、体育館に集い、たたえ合いたかったのですが、コロナ感染症防止の観点から、小学部は・・・
【オンラインでの参加です。(ただ、しっかりと映像、音声届いていました。便利な時代ですね。)】
【教室から大きな拍手を送り、気持ちを伝えます。あこがれの先輩の部活動での活躍を見ることができるのも、小中一貫教育校のよいところです!】
【わたしも〇〇部に入って、あんなふうに活躍したいなぁ・・】
今日の給食&上学ギャラリー(6/14)
【今日のメニュー】
〇麦ご飯、牛乳
〇魚の南蛮漬け
〇れんこん汁
今日の小さいおかずは・・・
「魚の南蛮漬け」です。油で揚げたものを酢や野菜と混ぜ合わせてあるそうです。
酢を使うと揚げ物でもさっぱりとした味になり、食欲をそそりますね!(体も柔らかくなりますかね?)
【上学ギャラリー】
今回の上学ギャラリーは・・・
【1年生の作品です!】
算数で勉強した「いろいろな形」の箱を使って表現・・・
【どれも楽しい作品ばかり・・・】
【タイトル「ぼうしをかぶったロボット」お目々ぱっちりの表情に癒やされる~】
【タイトル「かわいいおしろ」牛乳パックをうまく使っていますね!】
【タイトル「空飛ぶユニコーン」これは超大作!すごい!】
今日の給食&上学ニュース!(6/13)
ついに宮崎県地方も梅雨入りが宣言されました。
今日もずっと梅雨空で、肌寒かったのですが、給食を食べて心も体も温まりました。
【今日のメニュー】
〇チーズパン、牛乳
〇オムレツ、ブロッコリー
〇ポトフ
【上学ニュース】
こちらも心温まるニュースです。
本校を卒業された方(現在大阪在住)から、図書費にと寄付金をいただきました。変わらぬ上新田愛を感じ、大変うれしく思います。
図書支援員の先生と相談し、有効に使わせていただきます。誠にありがとうございました。
中体連速報(女子バレー)
本日、女子バレーボール準決勝、決勝が行われました。
準決勝
上新田 2-0 国光原
決 勝
上新田 2-0 唐瀬原
優勝です!おめでとうございます!
すべての試合でストレート勝ちの完勝でした!
県大会もがんばってください!
以上で全ての競技が終了しました。選手、指導者、保護者のみなさん、本当にお疲れ様でした。後日、熱戦の様子を学校アルバムに掲載しますので、ぜひ、ご覧になってください。
中体連速報(剣道、女子バレー)
○ 剣道団体戦
準決勝 上新田 4-0 妻
決 勝 上新田 3-2 西米良
優勝です!(県大会出場決定)おめでとうございます!
○ 剣道個人戦(県大会出場決定者)
優 勝 森 俊輔さん
第3位 岩切 利通さん
第5位 鬼塚 聖樹さん
おめでとうございます!
○ 女子バレーボール
2回戦 上新田 2-0 高鍋東
準決勝進出です!おめでとうございます!
新聞掲載のお知らせ(6/11)
6月11日(土)付、宮日こども新聞「学園俳壇」コーナーに、小学部5年生、四位 真麻さんの俳句が掲載されました。
おめでとうございます!
【掲載作品】
たんぽぽがふわっとどこかへ行ってきます
授業の様子(6/10)
今週最後の1本。授業の様子です。
まずは、中学部1年生「理科は感動だ!」から。
【メスシリンダーを使って・・・】
【じ~~~と目盛りを見つめる生徒・・・。1円玉(アルミニウム)の体積と質量を量って、密度を求める学習をしていました。】
続いて・・・
小学部2年生活科。学校の周りで見つけた植物の名前を・・・
【インターネットを活用して調べ中・・】
【「この花じゃない?」花の色や葉の形を見ながら相談中・・・】
ふるさとの自然に興味をもつよいきっかけになることでしょう。
もう1本2年生。図工の時間にお邪魔しました。
【作っているのは・・・】
【ふ・し・ぎ・な・た・ま・ご???見ててね!】
【パリ~ン!割れちゃいましたぁ!】
今週ラストは中学部2年生・・・
【グループで一生懸命調べ学習中】
【↑アクティブですねぇ!調べているのは?】
【修学旅行で行く長崎や熊本について・・・】
【しっかり下調べしておくと、実際に行ったとき、感動も倍増することでしょう。】
~授業の様子「お・し・ま・い」~
それではみなさん、よい週末をお過ごしください!
いのちの授業(6/10)
6月10日(金)、小学部4年生「いのちの授業」の様子です。
みやざき動物愛護センターから2名の先生に来ていただき、子ども達に、たった一つの「命」について、深く考えさせる授業を展開してくださいました。
【めあて「人と動物のつながりを学び、いのちについて考えよう」】
【犬や猫が当時殺処分されていた事実を真剣な表情で聞く子ども達】
【どんな動物を知っているかな?班で話し合います。】
【その動物は、「森」「牧場」「住宅地」どこに住んでいるかな?】
【「生きている」ってどういうことだろう?」】
「遊ぶこと」「考えること」「食べること」「うんこをすること」「心臓が動いていること」・・・
子ども達から様々意見が出てきました。
では、実際に・・・
【聴診器で心音を聞いてみよう!】
【うわ~~。すご~い!どっくん、どっくんいってる!】
【では、お互いに・・・。あなたも私も生きているのね!感動!】
聞こえづらかった人・・・
【スピーカーを通して聞いてみましょう!さぁ、〇〇君の心音は聞こえてくるのでしょうか?】
【聞こえる!聞こえる!よかった~~~!】

【「いのちのつながり」について。10代前まで遡ると、なんとご先祖様が1024人にもなるのです。そのうちの一人でも欠けてしまうと、今の自分は存在しない。】
「人間と動物のいのちのつながりについて」「自分のいのちのつながりについて」深く考えることのできた、学びの多い貴重な1時間となりました。
お忙しい中、来校していただき、素晴らしい授業をしていただいた「みやざき動物愛護センター」の外山様、安藤様、誠にありがとうございました。
次回(6/23(木))、「動物へのかかわり方を学び、共生について考えよう」も楽しみにしています。よろしくお願いいたします。
今日の給食&上学ギャラリー(6/10)
【今日のメニュー】
〇麦ご飯、牛乳
〇じゃが豚キムチ
〇枝豆サラダ
今年度から、月に何度か新富町の生産者の方に直接食材をセンターに届けていただいているそうです。
6月は、昨日のさつまいも、今日と16日のニラです。
地元の生産者さんが大切に育てた、安心安全な食材に感謝して・・・
いただきま~す!
【タイトル「ニラとにらめっこ!」】
☆上学ギャラリー☆
5年生の絵から紹介します。
【「心のもよう」:自分の気持ちや形や色で表すと・・・】
【タイトル「宝箱の奥の奥」】
【タイトル「心の中のきょうかい線」】
【タイトル「私の心の中とは」】
続いて小学部2年生・・
【粘土で表現していました。】
【タイトル「雪だるまのカフェやさん」*いやされる~】
【タイトル「きょうりゅうのなかまたち」*きょうりゅうたくさん作ったね!】
~つづく~
授業の様子②(6/9)
授業の様子PART2です!
まずは、6年生・・・
【調理実習「野菜炒め」】
【さすが昨年度「みそ汁づくり」で鍛えた実力は本物です!】
【あっという間においしい野菜炒めのできあがり!】
続いて中学部・・・
【教育実習生、音楽の授業です。】
【「オーケストラにはどんな楽器があると思いますか?」】
実習生とは思えない落ち着いた、そして楽しい授業でした。個人的に、ピアノが弦楽器だと初めて知りました。
続いて5年生・・・
【5年生国語「俳句を作ろう」】
【五・七・五だから(指を折りながら考え中)】
【む・む・むずかし~~~!】
【できた俳句をインターネットで投稿します。】
(投稿作品)
「海開き魚も私も日焼けする」
擬人法を使っていますね!お見事!
~6/9授業の様子「おしまい!」~
授業の様子①(6/9)
6月9日(木)授業の様子です。
小学部1年生が、タブレットを使ってお勉強中。
【すっかりタブレットにも慣れましたね!?どんな勉強をしているのかな?】
【「がっこうたんけん」の時の写真を見ながら・・・】
【どこにどんなものがあったのか絵と言葉で表していました。そして・・】
【各教室ごとに分類。たくさん見つけることができましたね!】
続いては・・・
中学部2年生体育「マット運動」です。様々な技に挑戦中。
【タブレットを使ってQRコードを読み取ると・・・】
【手本となる動画を見ることができます。それでは再び・・】
【チャレンジ!】
【開脚後転、かっこよくキメることができました。】
~PART2へ「つづく」~
今日の給食(6/9)
【今日のメニュー】
〇麦ご飯、牛乳
〇白身魚の天玉揚げ
〇さつま汁

今日の小さいおかずは・・・
「白身魚の天玉揚げ」です。
サクサクとした食感と青のりの風味が食欲をそそりました。
もしもに備えて・・・

6月8日(水)、教職員が「もしも」に備えて行った心肺蘇生法講習会の様子をお伝えします。
まずは・・・
【心肺蘇生法の流れを確認】
それでは実践です!
【周囲の安全を確認した後、反応の確認:「もしもし!もしもし!だいじょうぶですか?」】
【応援を呼びます:「AEDを持ってきてください」「119番通報してください」】
【胸骨圧迫(30回:1秒間2回のペース)】
【AEDを使用:「どうやって使えばいいのだろう?焦ってしまいそう・・・」】
【安心してください。全て音声ガイドが教えてくれます。】
心肺蘇生法について、記憶があやふやなところもあり、毎年行うことの大切さをあらためて感じました。
これから水泳指導が始まります。もしも(もちろんないにこしたことはないのですが)が起こってしまったとき、今日の研修を活かし、落ち着いて行動したいと思います。
あわせて・・・
【中学部生徒も体験しました。】
【協力しながら、命を守る学習を行っていました。】
60万アクセス突破!(6/8)
6月8日(水)、午後8時くらい、本校ホームページアクセス数が、60万人を突破しました。
1日平均、約1000人もの方々にご視聴いただいている計算です。本当に、うれしく思いますし、責任感も感じております。
今年度目標「80万アクセス」を目指し、今後も、上学の魅力ある教育活動を毎日配信してまいりますので、度々のお立ち寄りを心よりお待ちしております。
少年団も大活躍!
昨日は、野球部の大活躍をお伝えしましたが、小学生も負けずに優秀な成績を収めています。
紹介します。
【宮崎県選抜野球大会児湯予選】
〇 上新田小少年野球 13-3 通山イーグルス
〇 上新田小少年野球 5-1 新田小少年野球
〇 上新田小少年野球 7-1 高鍋東小少年野球
見事優勝!!7月23日、24日に行われる県大会へ出場します!
おめでとうございます!
続いて・・・
【第39回戦没者慰霊奉納剣道大会】
〇 小学2年生の部
優 勝 鬼塚 丈瑠さん
準優勝 新惠 清越さん
第3位 熊ノ迫 玲音さん
〇 小学3、4年生の部
優 勝 新惠 一馬さん
〇 小学5、6年生の部
第3位 勝川 敬介さん
〇 中学団体の部
優 勝 上新田中B
準優勝 上新田中A
おめでとうございます!
今日の給食(6/8)
【今日のメニュー】
〇コッペパン、牛乳
〇ビーフシチュー
〇ハムマリネ
【デミグラスソースに柔らかい牛肉が溶け込んでいて美味でした!】
アドバイス会(6/8)
朝の時間、中学部の先生に声をかけられていってみると・・・
6月27日(月)、28日(火)にかけて行われる、中学部「定期テスト」に向けてアドバイス会を行っていました。
アドバイス会とは・・・
初めてテストを受ける中学部1年生に・・・
経験豊富な先輩から、テスト勉強の方法等をアドバイスする会です。
【歴史は流れを考えながら覚えていくといい。地理は・・・。的確なアドバイスが続きます。】
【まずは、テスト範囲をしっかりつかむこと!】
【これまでの体験に裏打ちされた、貴重な一言一言を真剣な表情で聞く1年生】
1年生の学力向上はもちろん、生徒間の絆も深めることのできる素晴らしい交流だと感じました。
中体連速報(決勝戦)
野球部、決勝戦の速報です。
〇 上新田中 0-7 唐瀬原中
秋の大会も制している王者唐瀬原中に、食らいついていきましたが、力及ばずでした。
しかし、堂々の準優勝!(県大会出場)帰校してきたら大きな拍手を送りたいと思います。
さぁ、今週末は、剣道部、女子バレー部が登場します。今は体調を整えて、本番で力が発揮できるように、そなえて欲しいと思います。
【16:00】
野球部が凱旋帰校してきました!
【大満足のガッツポーズ!県大会も頑張ってください!】
今日の給食&上学ギャラリー(6/7)
【今日のメニュー】
〇麦ご飯、牛乳
〇大豆の五目煮
〇きゅうりとわかめの酢の物
クイズです!
お米と相性ピッタリ、日本で昔から食べられているものなぁ~んだ?
①牛乳 ②大豆 ③牛肉 ④ふりかけ ⑤ごはんですよ
正解は・・・
【もちろん大豆です!(②)】
大豆には、お米に不足しているアミノ酸という栄養をたくさん含んでいるそうですよ。
大豆たっぷりの五目煮、今からよく噛んでいただきます。
【上学ギャラリー】
6月になり、毎月楽しみにしている・・・
【図書館掲示物リニューアル!】
6月といえばやはり・・
【あじさいにカタツムリですね!】
これから梅雨入り。憂鬱な気分を図書館の本と掲示物がいやしてくれることでしょう。
中体連速報(6/7)
本日、準決勝を戦った野球部の速報です。
〇 上新田中 2-0 富田中
3試合連続の完封勝利!
見事決勝戦進出(県大会出場)です!
この後、唐瀬原中と決勝戦を行います。
昼からも声援を送り続けましょう!
中体連速報(6/6)
【軟式野球】
〇1回戦 上新田中 7-0 都農中
〇2回戦 上新田中 2-0 高鍋西中
2試合連続の完封勝利で準決勝進出!
明日、決勝進出(県大会出場)をかけて、富田中と戦います。
【男子ソフトテニス】
〇1回戦 上新田中 0-3 西米良中
3年生らしいプレーを随所に見せてくれました。
(個人戦)
〇須藤、森山ペア 2回戦進出
【女子ソフトテニス】
1回戦 上新田中 1-2 穂北中
大接戦となりましたが、僅差で敗れてしまいました。
(個人戦)
〇甲斐、神田ペア2回戦進出
〇長友、小山田ペア3回戦進出
授業の様子(6/6)
今週も始まりました!
授業の様子からスタートです!
まずは、5年生家庭科。
子ども達がテレビ画面を見ながら、寄り目になって、糸を操っています。何をしているのかというと・・・
【裁縫の基本、「玉留め」。上手にできてうれしそう・・・】
【さすが先生!「必〇仕事人」。あっという間に、くるりんパッ】
2年生教室からきれいな音が聞こえてきたので入ってみると・・
音楽のお勉強。現在、新型コロナ感染症拡大防止の観点から、リコーダーや鍵盤ハーモニカを使用できないので・・・
タブレットの「ピアノ機能」を使って演奏会。
きれいな音が出るとうれしそうにしていましたが、早く、生演奏をしたいですね。
最後に・・
小学部1年算数「いろいろなかたち」
これまでに・・・
いろいろな形の仲間分けをしてきた子ども達。この日チャレンジするのは・・・
【積み木の・・・】
【円や、四角、三角の面を写し取って・・・】
【かわいいお絵かき・・・。】
【次から次へとアイディアがあふれてきますね!】
楽しいお絵かきを通して、立体の面の形を意識しはじめていた子ども達です。
~つづく~
今日の給食(6/6)
【今日のメニュー】
〇コッペパン、牛乳
〇鶏肉のフォー
〇小松菜とウインナーのソテー
今日の大きいおかずは、ベトナム料理でライスヌードルの・・・
「鶏肉のフォー」です。お米の麺と鶏肉の出汁が合っていて、とてもおいしかったです。
【Are You Hungry?Rice Noodle!】
それではみなさんご一緒に!鶏肉の~
【フォー!!(失礼しました~!)】
今日も、中体連の熱戦が続いています。
参加する選手の皆さん、
【ファイト~~!(この後、ジャムがたれてきて手がベタベタに…。)】
これから結果が届き次第、速報でお伝えしていきます。
新聞掲載のお知らせ(6/4)
6月4日(土)付、宮日こども新聞「学園歌壇」コーナーに、2名の生徒の作品が掲載されました。
おめでとうございます!
○ 川上 なつさん(中学部1年)
「一日が早く感じるなぜだろうなんだか悲しい不思議な気持ち」
○ 永友 心和さん(中学部1年)
「鶯(うぐいす)よその鳴く声は風にまぎれ春感じさせ心揺さぶる」
今日の給食&上学ニュース!(6/3)
【今日のメニュー】
〇麦ご飯、牛乳
〇里芋のそぼろ煮
〇かみかみきんぴら
今日は「かみかみかみにゅーたデー!」です!(勝手に命名)
小さいおかずは・・・

【かみかみ金平】
中身は、ごぼうに茎わかめなど、その名の通り噛みごたえのある食材が使われていました。
そして、6/4~6/10まで・・
【歯と口の健康週間です】
今年のテーマは、「いただきます 人生100年 歯と共に」
よく噛んで食べて、むし歯のない丈夫な歯をつくりましょう!
授業の様子(6/3)
暑さに負けず、勉強をがんばる上学っ子の様子をご覧ください。
4年生総合的な学習の時間「座論梅博士になろう」の授業の様子です。
教卓に置かれているものは・・・
【ダ~~ン!座論梅で収穫した梅です!】
【これから、梅干しや梅ジュースに生まれ変わります。楽しみですねぇ~。】
さて、今日は梅の何を勉強しているかというと・・・
【タブレットを活用し、何か一生懸命調べています。】
【梅の栄養(効能)について調べ、ノートに書き込んでいました。】
【え~と、「消化吸収を助ける」「整腸作用がある。」・・・。美肌効果もあるんだ!(これから先生も毎日食べることにする!)】
小学部6年生の教室でも・・・
【タブレットを活用して・・・】
【情報モラルについて学習していました。】
続いては、理科は感動だ!コーナー
中学部3年生理科。めあては「硝酸銀水溶液に銅をいれるとどうなるだろう?」
今回も何か危険なかおりが・・・
【BEFORE:硝酸銀水溶液に銅を入れると・・・、どうなる?】
【AFTER:銅が銅イオンになって水に溶け出した!銅の周りに付着しているのは、水溶液に溶けていた銀イオンが銀になったものです。見えなかったもの(銀)が見えるようになったんですね!これは驚きです!】
↑この説明で理解していただけるかどうか不安ですが・・・。
~つづく~
小さな旅⑤(6/2)
今日も上学の何気ない、ただちょっと心が温かくなったり、クスッと笑ったりする(してくれたらうれしい・・)「小さな旅」をお届けします。
【昼休み、キャッキャ、キャッキャとにぎわう4年生。何がそんなに楽しいの?】
【アマガエル~~!かわいいですねぇ!?捕まえた3人で飼うことにしたそうですよ。だから名前は「三太郎」】
水曜日の昼休み・・・
【ハンドベルクラブが恒例の練習を行っていました。そこに・・・】
【中学生の姿が・・・。昨年までハンドベルクラブに所属していたOGです!】
【毎週水曜日、練習に来てくれているのだそうですよ!なんて素敵な先輩なんでしょう!】
【放課後の小学部多目的ホール】
【真っ赤な少年発見!一生懸命勉強していました。】
【私がカメラを向けても、知らん顔・・のこの集中力。すごいですねぇ~!】
【清掃時間の写真ではありません!なんと・・・】
【6年生が朝のボランティアをしてくれていました!学校も心もきれいになりますね。ありがとう!】
最後に、私と同じ・・・
【大の「ジャイア〇〇ファン」発見!今年こそは・・・】
~小さな旅PART6へ「つづく」~
今日の給食&上学ニュース!(6/2)
【今日のメニュー】
〇麦ご飯、牛乳
〇さばごま味噌煮、ゆでもやし
〇なめこ汁
今日は・・・
【みそ汁に(なめこ汁)・・・】
【「青魚の王様!」さばの味噌煮】
ご飯との相性ぴったりの和食デーでした。
【上学ニュース!】
6月2日(木)、中学部1~3年生参加の「高校入学説明会」が行われました。
【各高校のプレゼンを・・・】
【真剣な表情で聞く生徒達】
お忙しい中、来校していただいた各高校担当者の皆様、生徒の進路選択に役立つ情報をたくさんいただき、誠にありがとうございました。
授業の様子②(6/1)
6月1日(水)、「授業の様子」PART2です。
6年生図工「デザイン画」の学習です。
【木工用ボンド???】
【ドライヤー???】
【クレヨンを使って…。美しい模様があらわれてきました・・・】
【う~んカラフル!すばらしい~~!】
続いては、小学部クラブの時間・・・
【家庭科クラブにお邪魔しました。】
【作っているのは・・・】
【コースター!】
【コースターのファッションショーや~~!】
【パソコンクラブも活動中!パソコンで作った作品が完成したようです。】
【オリジナルカレンダー。パソコンを使うととってもきれいに作れるね!】
それでは、今日はこのへんで・・・
See You Tomorrow!
11月④12月①
今年も最後の1か月…1年が経つのは早いですね。11月の終わりから、身体を温めるメニューが多くなってきました。おでんにポタージュ、豚キムチ丼です!チリコンカンも給食によく出るメニューの一つですね。メキシコ風のアメリカ料理です。チリコンカンはスペイン語で「チリコンカルネ」と呼ばれ、「チリ」は「唐辛子」、「コン」は「と」、「カルネ」は「牛肉」という意味があります。名前の通り牛ひき肉をチリで煮込んだ料理で、そこに定番食材の豆やトマトを入れ、栄養バランスの良いメニューとなっています。(給食には、唐辛子は入っていません。)献立表を見るとき、メニュー欄だけでなく、使われている食材や調味料の欄もぜひ見てほしいと思います(*^_^*)
11月①ヴィアマテラスの選手と(*^^*)
11月5日(水)は、ヴィアマテラス宮崎の選手が9名来校し、子どもたちと一緒に給食を食べました。この日のメニューは「米粉パン、牛乳、秋のかおりシチュー、花野菜サラダ」でした。シチューの中には、秋を代表するさつまいもやしめじがたっぷり入っていました。選手や学級の仲間と食べる給食はとてもおいしかったですね!一人で食事をするより、食事をする相手がいる方がより幸せを感じるそうです(*^▽^*)給食の後は、選手と一緒に運動場でサッカーをしたりおにごっこをしたり、みんなで楽しい時間を過ごすことができました!
9月③④⑤
9月後半の給食です。みんなが大好きなポークカレーにバーガーパン、豚キムチ丼!イタリアンスープの中には、ラビオリが入っていました。(ラビオリとは、パスタ生地の中にひき肉や野菜、チーズなどを挟んだものです。)そして、9月最後の日には「うなぎのかば焼き」が出ました(*^^*)今年も中村養鰻場さんからの提供により、おいしいうなぎを食べることができました。ありがとうございました。栄養価の高いうなぎは、体育大会の練習をがんばっている子どもたちにぴったりの食材です。今日から10月…体育大会までのこり2週間です!(^^)!早寝早起き・朝ご飯はもちろんのこと、バランスのよい食事を心がけて、万全の体調で臨みましょう!
7月③★夏休みがはじまるよ!★
7月最後の週は、チャンポンにホットドックパン!シメは、夏野菜カレー(^_^)なすやピーマンがたくさん入っていました。おいしい給食を毎日ありがとうございました。みんなもりもり給食を食べているかなと教室をのぞいてみると、上新田から転校する子と別れを惜しんで、みんなで給食を食べている姿が見られました。さびしいですね…でもきっと新しい学校でもがんばってくれることでしょう。上新田っ子、みんなで応援していますよ!(8月の給食へとつづく~)
7月①②~給食試食会~
夏休みまで、のこり1週間…子どもたちは、厳暑の中よくがんばっています。7月に入って、季節にちなんだ花野菜サラダや七夕ゼリーが出ました。涼を感じるメニューでしたね。7月10日(木)は、給食試食会が行われ、保護者の皆様に学校給食の献立や味、栄養を知っていただく機会となりました。今年も新田学園の栄養教諭・渡部先生を講師としてお招きし、給食の栄養バランス等についてお話していただきました。保護者の皆様は「毎日、給食食べたいね。」「おいし~い!」と笑顔いっぱいでした(*^_^*)今週は、子どもたちが大好きなホットドック、そして夏野菜カレーで1学期をしめくくります。登校するのもあと4日!元気に過ごしましょう~
〒889-1406
宮崎県児湯郡新富町大字新田17053番地8
電話番号(小)0983-35-1016
(中)0983-35-1017
FAX (小)0983-35-1305
(中)0983-35-1286
E-mail 4520ja@miyazaki-c.ed.jp
本Webページの著作権は、「学びの丘 上新田学園」が有します。無断で、文章・画像などの複製・転載を禁じます。
【校訓】

| 日 | 月 | 火 | 水 | 木 | 金 | 土 |
29 | 30 | 31 | 1 | 2 | 3 | 4 |
5 | 6 | 7 | 8 | 9 | 10 | 11 |
12 | 13 | 14 | 15 | 16 | 17 | 18 |
19 | 20 | 21 | 22 | 23 | 24 | 25 |
26 | 27 | 28 | 29 | 30 | 1 | 2 |